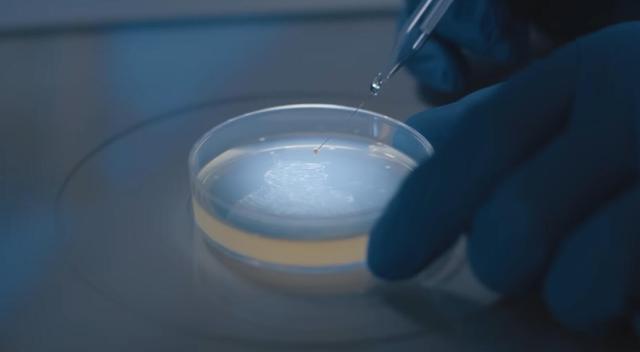

英雄联盟投注 地球里面果然存在人命!科学家发现地下生物圈,生物种类少见百万
发布日期:2026-04-14 14:39 点击次数:93

在上世纪20年代,东说念主们在矿井开拓和深井汲水等工程举止中,发现了一个奇怪的时事,那便是从地下数百米深处的抽上来的地下水中,竟然存在着人命举止的迹象。
之是以说这件事“奇怪”,是因为按照那时的科学贯通,在如斯深的地下,根底就不具备人命存在的基本要求,因为那边莫得阳光,温度和压力皆远超地表,氧气也极为稀缺,也莫得什么可应用的养分物资。
不外这种时事那时并莫得掀翻太大海潮,因为全球大皆以为,这应该是样本被耻辱了。但跟着期间的荏苒,雷同的时事却在握住地发生,这使得越来越多的科学家开动怀疑,难说念说地球里面确实存在人命?
到了上世纪70年代,科学家筹算了严格的取样经由(比如使用无菌钻探、密封采样、同位素示踪等技巧),在确保样本没被耻辱的情况下索求了多种地下深处的样本,死一火已经发现了人命举止的脚迹。
而这也就意味着,之前怀疑对了,地球里面果然存在人命,于是相干的推敲就此确认开动。
干预21世纪之后,相干推敲迎来了信得过真谛上的系统化发展。跟着深海钻探时代、超深井工程以及分子生物学快速跳跃,科学家得以从全球圭臬对地下人命进行全面看望,并缓缓发现了一个鸿沟渊博的地下生物圈。

这些地下生物并不是咱们遐想中那种掩饰在地底的怪兽,本色上,它们基本皆是以细菌和古菌为主的微生物,除此以外,还有少许的真核生物。
推敲标明,这些地下生物散布的范围相配广,从大陆深处的岩层,到海底千里积物之下,再到洋壳里面的裂隙系统,开云体育官方网站 - KAIYUN到处皆存在着它们的身影,其范围在大陆之下不错蔓延到梗概10公里深的地点,而在海洋区域,如若从海面算起,最深不错达到约21公里。
更引东说念主慎重标是,这个地下生物圈的生物各样性以及生物量远超预期,凭据连年来多项笼统推敲的估算,其生物种类少见百万之多,总生物量可达150亿至230亿吨(无意额外于地表细菌和古菌总生物量的9倍)。
科学家发现,这些微小的人命不依赖阳光进行光互助用,也不需要从外界接纳现成的有机物,而是径直应用无机化学响应来赢得能量和构建自己,其中最主要的能量开首是氢气。

要知说念地下环境中,氢气并不是寥落物资,反而开首额外丰富。比如说岩石中自然存在的辐照性元素在衰变过程中,会解析水分子,开释出氢气,英雄联盟比赛投注某些矿物与水发生响当令,也会生成氢气(其中一个典型过程是橄榄石改变为蛇纹石),而在地壳受力发生剪切和摩擦时,也能通过机械作用产生氢气。
而这些微生物则进化出了一个专门应用氢气的用具——氢化酶,这种卵白质不错高效捕捉氢气并参与能量革新,推敲标明,在深层样本中,氢化酶的基因数目昭着高于地表微生物,讲解它们在这里是“主力装备”。
有了氢气之后,这些微生物会把二氧化碳手脚碳源,通过一套自己的代谢旅途将其复原,生成有机分子,同期开释能量。
除了氢气,一氧化碳和甲酸盐亦然常见的能量开首。在高温要求下,岩石与水的界面不错当然生成这些小分子,微生物不错径直加以应用,与此同期,硫酸盐、硝酸盐以及各样金属氧化物不错手脚电子受体,参与雷同呼吸链的响应,匡助完成能量开释。

专门念念的是,这些微生物时常会酿成小鸿沟的群落,通过代谢互补来晋升全体效果。
比如说一些产甲烷的古菌会与硫酸盐复原菌酿成共生关系,一个产生中间居品,另一个连续应用,把能量链条串联起来,而病毒在这里也不是“旁不雅者”,它们通过感染和基因改变,匡助微生物快速得当环境变化。
科学家还发现,这些微生物的弃旧容新速度远低于地表生物,有的细胞可能几年以至几十年才离别一次,但慢并不等于脆弱,相背,这是一种极点稳当的生活政策,这使得它们不错在抓续但微细的能量输入下,始终保管人命举止。
科学家暗示,就咫尺的情况来看,咱们对地下生物圈的了解还极为有限,但不错笃定的是,这些生活在地球里面的人命一直在参与地球的基本运作,它们影响着碳轮回、硫轮回和氮轮回,在地下深处安祥但抓续地改变着矿物构成和化学环境。

而更专门念念的,则是它们对外星人命推敲鸿沟的启发,毕竟往日咱们寻找地外宜居环境时,时常优先琢磨雷同地球名义的要求,比如有阳光、有液态水、温度适中,但咫尺看来,唯一有水、有基本的化学能量开首,哪怕在高温高压的地下环境中,人命已经不错存在。
无意咱们一直寻找的外星人命英雄联盟投注,可能就安身于某颗星球的地下深处,即使是太阳系中也存在着它们的身影(比如说火星、土卫六、木卫二等等)。
开云app官方下载- 上一篇:lol投注app 好意思动力部长改口称油价或抓续攀升,特朗普承认影响中期选举
- 下一篇:没有了

备案号: